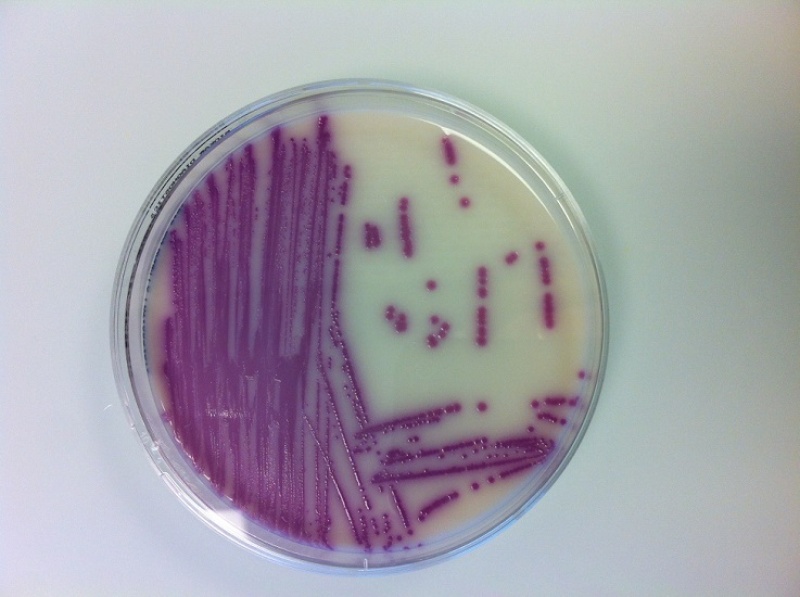

Le laboratoire de biologie alimentaire effectue notamment les analyses microbiologiques des denrées alimentaires et des objets usuels, prélevés officiellement lors d’inspections effectuées par le service.
Il procède également aux analyses microbiologiques des eaux potables, que les distributeurs apportent au service dans le cadre de leur obligation d’autocontrôle. Lors d’enquêtes relatives à d’éventuelles intoxications alimentaires, il est en outre amené à rechercher la présence de germes voire de toxines à l’origine des troubles de santé. Le Laboratoire de biologie alimentaire est accrédité selon les normes ISO/CEI 17025 (laboratoire d'essai - no d'accréditation STS 0161). Les microorganismes recherchés sont :
- les germes d’altération indicateurs d’un non-respect de l’hygiène des procédés de fabrication et de mauvaises pratiques dans un établissement (par ex: chaîne du froid non respectée, préparation à l’avance, conservation prolongée) ;
- les agents pathogènes responsables d’intoxication ou de toxi-infections alimentaires, tels Listeria, Salmonella, Campylobacter, etc., qui sont des micro-organismes importants en microbiologie alimentaire.
L’Ordonnance sur l’hygiène fixe les critères microbiologiques définissant l’acceptabilité d’un produit, d’un lot de denrées, d’un procédé ou d’un objet usuel (art 5. OHyg ).
Enfin, le laboratoire de biologie alimentaire procède également aux analyses microbiologiques des eaux de piscines et des plages publiques de baignade.